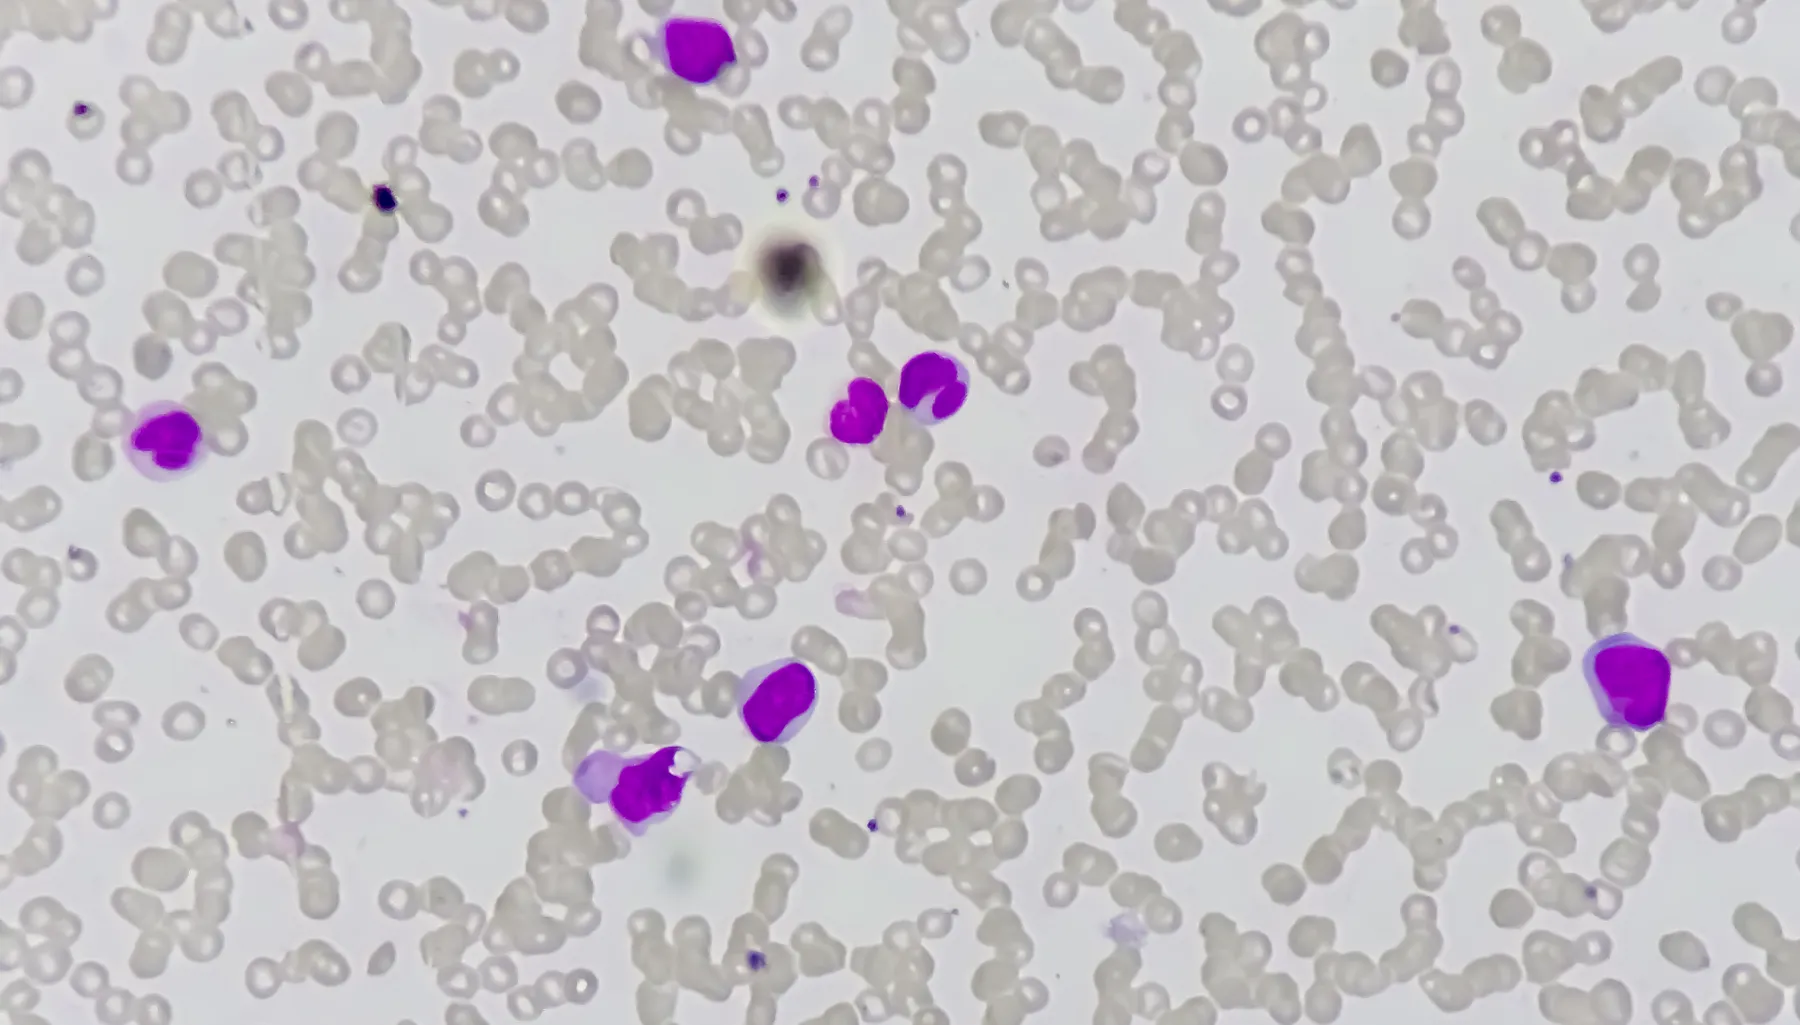
Acute myeloid leukemia (AML). Red blood cell. Blood smear microscopic 100x image.

Nearly 8 years ago, the first CAR T therapy was approved by the FDA for the treatment of B cell acute lymphoblastic leukemia (ALL). This breakthrough therapy used the patient’s own modified T cells to seek out and destroy cancer cells. Since then, six more CAR T therapies have been approved to treat forms of lymphoma, leukemia and multiple myeloma, with many patients experiencing lasting remissions.
However, to expand the range of diseases that can be treated with CAR T – as well as address the major manufacturing and cost challenges associated with cells therapies – new techniques and technologies must be developed, tested, scaled, and deployed to patients in need. As part of the Danaher Beacons program, teams at the University of Pennsylvania's Center for Cellular Immunotherapies (CCI, founded by CAR T pioneer Carl June) and Cytiva, a Danaher operating company, are working together to optimize a workflow for engineering human stem cells using lipid nanoparticle (LNP)-mediated delivery of gene editing enzymes. This optimized delivery method may enable new cell therapies that address major clinical unmet needs and may set the stage for a single CAR T product to treat a majority of blood cancers.
All about the antigens
In traditional CAR T treatment, T cells are extracted from the patient and programmed to express a protein (the chimeric antigen receptor, or CAR) on their surface that recognizes a specific protein on the surface of the target cells (the antigen). When the antigen and CAR interact, the T cell destroys that target cell. Since CAR T cells will kill any cell displaying that antigen, an ideal CAR T treatment would target an antigen that is only expressed on malignant cells and not on normal cells. However, disease-specific antigens that are suitable for targeting by CART cells are vanishingly rare. In the case of B cell ALL, the CAR T treatment was instead designed to attack all B cells. “This approach works because we can live without normal B cells. Unfortunately, we cannot live without hematopoietic stem cells and their myeloid progeny, which are the normal cellular counterparts of acute myeloid leukemia, or AML,” says Dr. Saar Gill, MD, PhD, an Associate Professor of Hematology-Oncology in the Perelman School of Medicine. In AML, cancer affects hematopoietic stem cells and myeloid progenitor cells, which normally produce monocytes, dendritic cells and granulocytes, all of which are responsible for defending the body against infection. “Without myeloid cells, patients can’t survive very long, so we needed a new approach to treat AML with CAR T,” he says.
This new approach sounds counter intuitive – at first. “The novel idea here is that we are targeting a receptor, CD45, which is expressed on all nucleated blood cells. This means that if we released this CD45-targeting CAR T in an unprepared patient, it would kill all blood cells whether they were benign or malignant, and also very likely the patient,” explains Dr. Friederike Herbst, PhD, the director of the Human Genome Editing Lab at the CCI at Penn. She continues, “The key step is that we must first generate a hematopoietic system that is invisible to this cell therapy, that way the CD45-targeting CAR T cells only attack the cancer cells.”
Editing for invisibility
To develop this invisible hematopoietic system (i.e., all the blood-forming tissues and circulating blood cells in the body), the CCI team is leveraging the gene editing technology known as base editing. “Base editing is a highly precise way of changing one DNA base into another, which could allow you to turn a gene on or off, or change its expression level, or in this case, prevent recognition by an antigen receptor,” says Dr. Gill. “CD45 is an essential protein, meaning that its function must be maintained, but we found that we can use base editing to change just the sequence that directly interacts with the CD45-targeting CAR. In this way, the CAR no longer recognizes these cells and will not kill them.”
To repopulate a patient’s body with this invisible hematopoietic system, the CCI team is advancing the use of base editors in HSPCs, or hematopoietic stem and progenitor cells. “This is a very diverse population of cells that can give rise to the full complement of immune cells,” says Dr. Herbst. The idea is that HSPCs are extracted from the patient, edited ex vivo, then replaced and allowed to divide and differentiate into a functional and CAR T-cell invisible hematopoietic system. Then the CD45 CAR T treatment is administered. The challenge is that editing HSPCs is no easy feat.
The devil is in the delivery
One of the biggest hurdles in genome engineering is getting the editing machinery inside the cell. “We express the CAR using a modified virus as the shuttle into the T cell. This results in a consistent expression of the CAR for the life of the cell. However, we can’t use this same approach for delivering the base editor into the HPSCs because there we only want the base editor to be expressed for a short time period, what we call ‘transient expression.’ Without transient expression, we risk off-target edits and thus toxicity,” explains Dr. Herbst.
The standard method for delivering genetic material for transient expression in cells is called electroporation, and it uses a brief electric current to disrupt the cell membrane. However, “Cells don't like being electrocuted and zapped,” says Dr. Gill. “We can only extract a limited amount of HSPCs from a patient and so we must make sure they are healthy and happy. A lot of cells die during electroporation and that means you may not have enough cells to treat the patient.”
The CCI team is working with Cytiva to test and optimize a different approach: lipid nanoparticles, or LNPs. “LNPs are a mixture of four different types of lipids that protect and deliver genetic material, such as the RNA sequence for the base editor in this case, into cells,” says Dr. Samuel Clarke, Director of R&D at Cytiva. “LNPs have several important benefits that are essential for enabling the HSPC base editing application. First, they are able to create a relatively high amount of viable cells. Second, treatment of cells with LNPs considered to be a consistent and replicable process. Third, we’ve developed a scalable LNP manufacturing platform. These benefits facilitate rapid clinical translation of LNPs into new applications.”
Collaboration is the key
Launched two years ago, this collaboration has yielded positive results.
“The Beacon is a great initiative because it brings together our expertise in gene editing and patient care with Danaher’s unique technologies and industry perspective. Together we’ve created a workflow to genetically engineer both T cells and HSPCs using LNPs,” says Dr. Herbst.
This work is an important step towards developing a CAR T treatment for AML. “AML is a very aggressive disease. The overall survival rate is really low and there are no proper treatment modalities available to efficiently treat those patients. We believe that our strategy with this LNP-modified product will make a big difference for these underserved patients,” she continues. “But what is really exciting is that because CD45 is expressed on all nucleated blood cells, this treatment strategy could be applied to a huge range of hematopoietic disorders, whether they are T cell malignancies, B cell malignancies, myeloid malignancies, multiple myeloma or autoimmune diseases.”
This collaboration also addresses two of the other major hurdles when it comes to cell therapies: manufacturing and cost. “To make cell therapies more accessible to patients, we need to address the manufacturing process. Our work shows that LNPs can increase the total number of edited cells, and this potentially streamlines and improves transferability of the whole manufacturing process,” Dr. Gill.
Dr. Herbst adds, “Today LNPs are helping us to generate a high number of patient-specific edited HSPCs ex vivo, but in the future with additional development they could enable us to create an off-the-shelf cell therapy product or to execute the editing step directly in a patient’s body,” Dr. Herbst explains. “Both of these approaches have the potential to drastically reduce manufacturing costs and make cell therapy easier to deploy to patients in need.”
The benefits from this work have not been one sided. “We’ve learned a lot from the CCI team as they have rigorously tested our T cell and HSPCs LNP kits to achieve successful base editing, a new application for these LNP kits. And with Cytiva’s new biomanufacturing facility coming online, we are well-positioned to support CCI to translate these LNPs into clinical trials,” says Dr. Clarke. “As a scientist, there’s nothing more rewarding than the opportunity to see patients benefit from your work.”
University of Pennsylvania Financial Disclosure: The laboratories of Drs. Gill and Herbst have received sponsored research funding from Danaher.